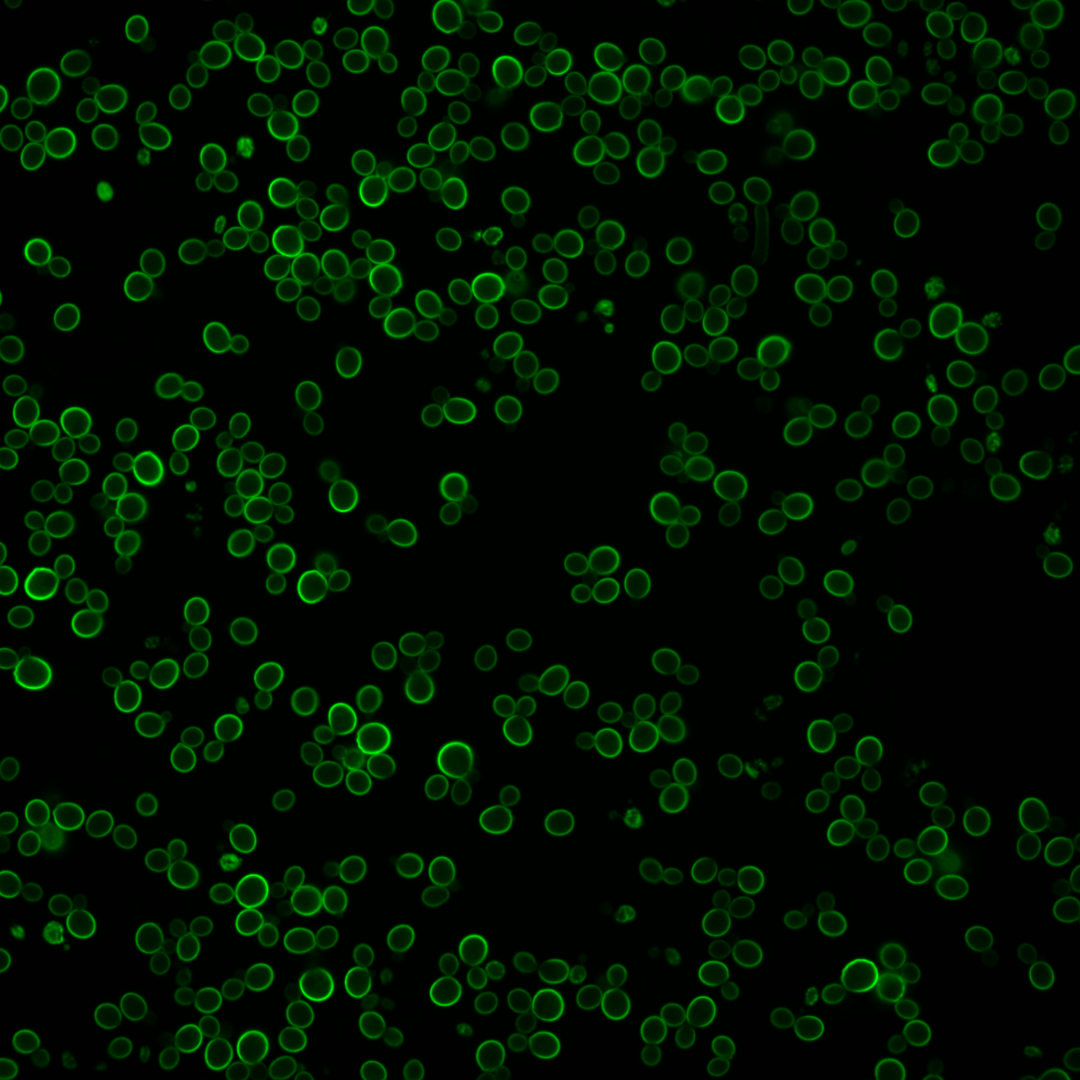
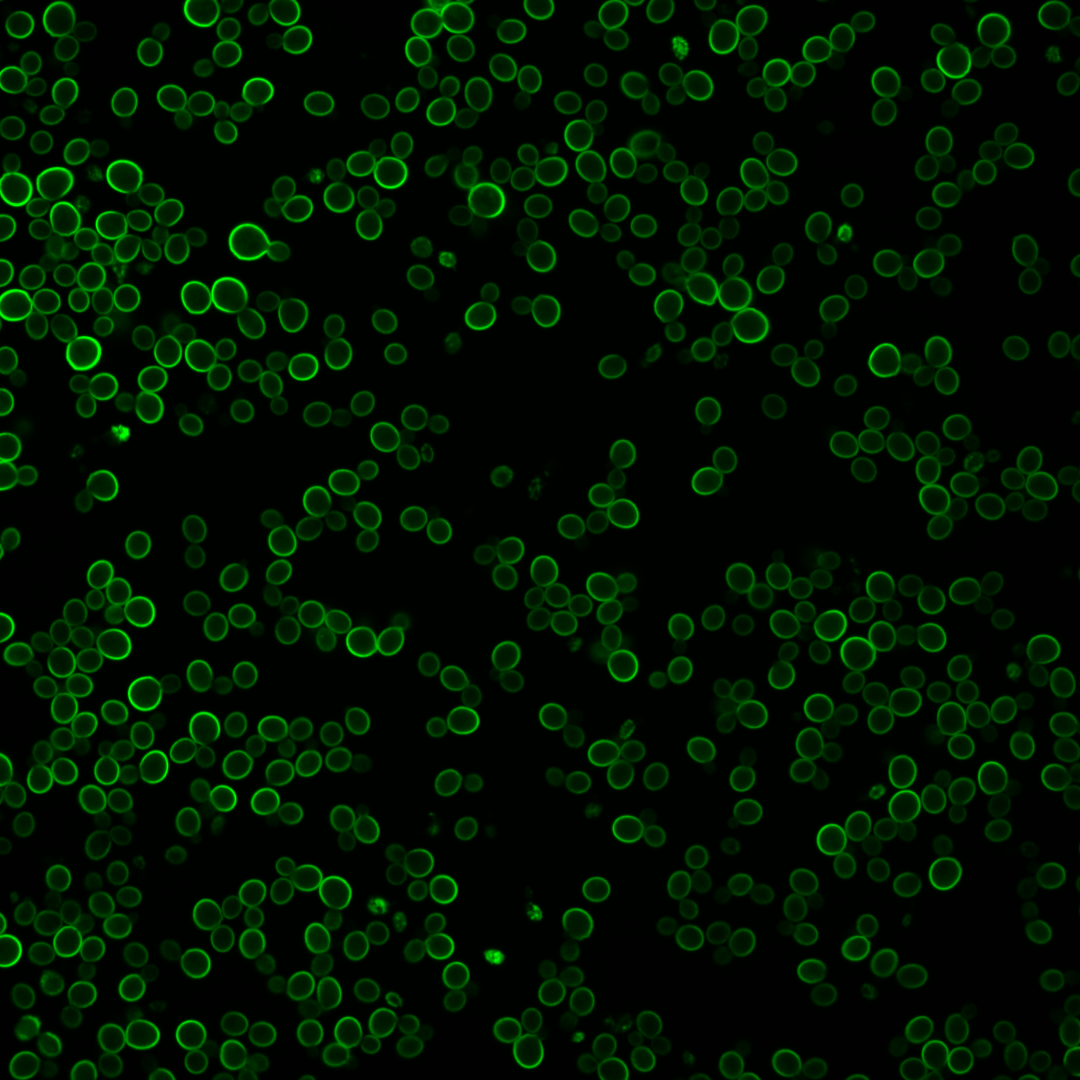
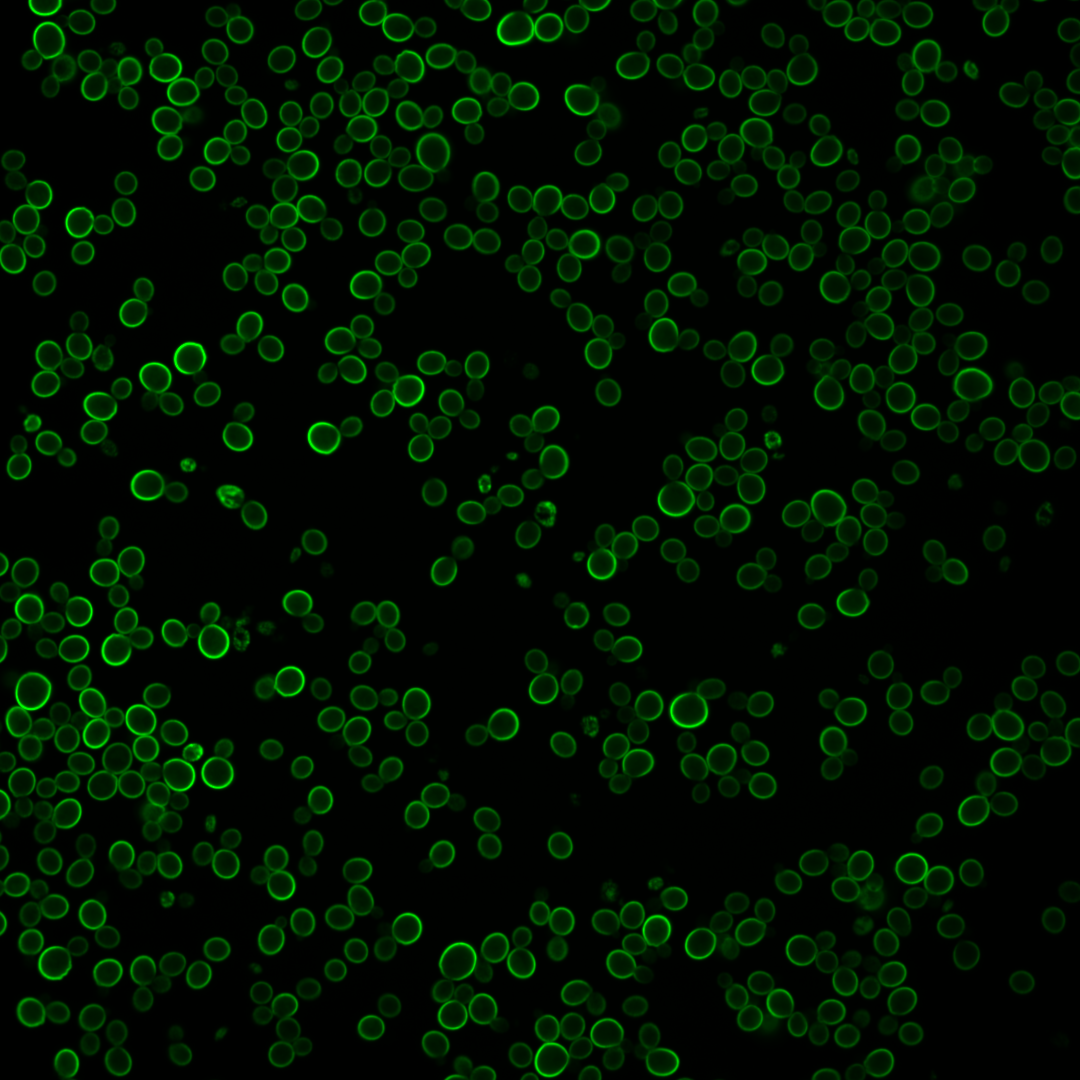
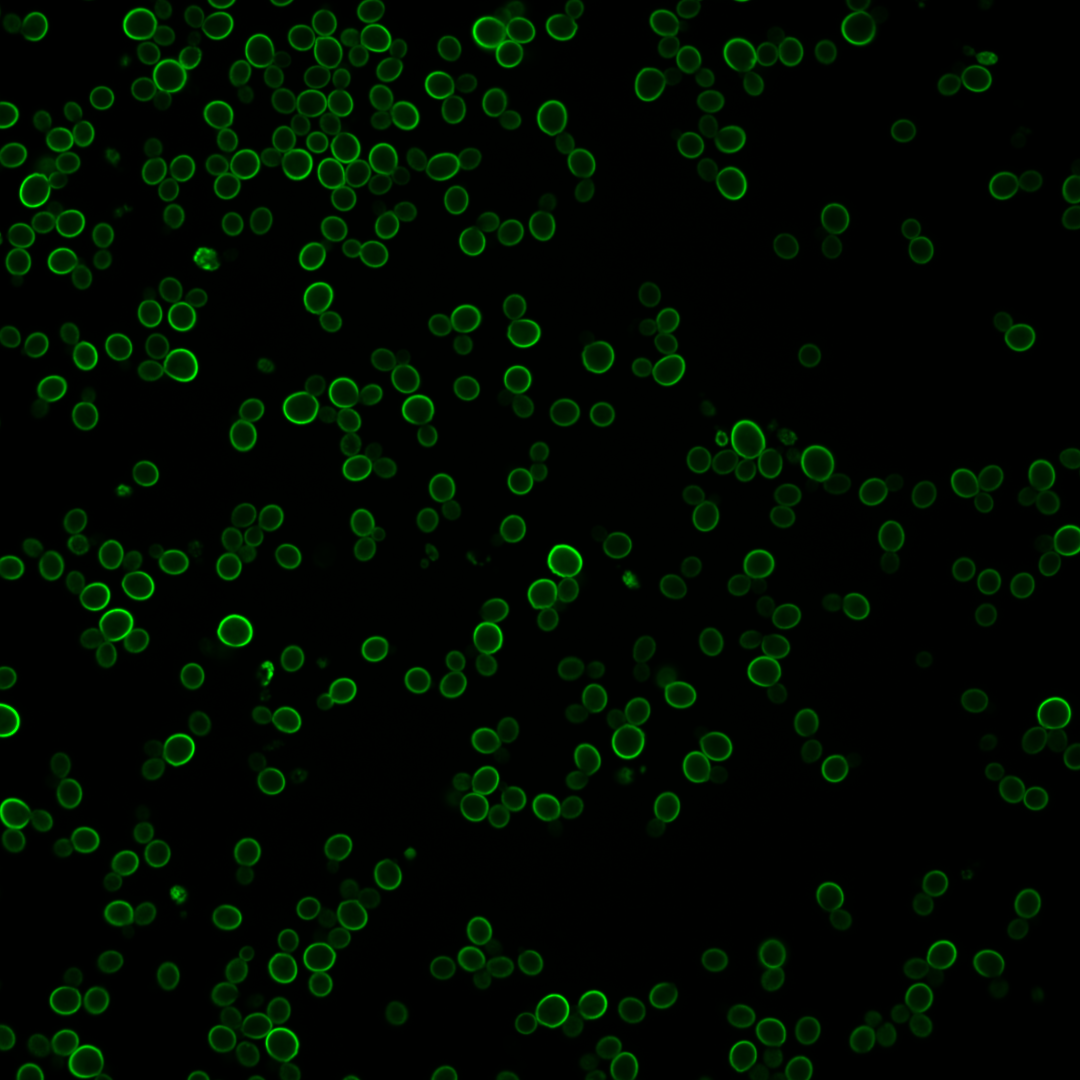

| Standard name | |
|---|---|
| Human Ortholog | |
| Description | Ammonium permease involved in regulation of pseudohyphal growth; belongs to Mep-Amt-Rh family of well-conserved ammonium (NH4+) transporters that includes human Rh factors; expression is under the nitrogen catabolite repression regulation; activity is controlled by phospho-silencing; phosphorylation of Mep2 mediated by Npr1; dephosphorylation involves Psr1p and Psr2p |
Micrographs




















































































Sub-cellular Localization
Yeast GFP Assignment
Protein Abundance
Localization Change
External localization resources
| ensLOC | DeepLoc | |||||||||||||||||||||||
|---|---|---|---|---|---|---|---|---|---|---|---|---|---|---|---|---|---|---|---|---|---|---|---|---|
| Localization | WT1 | WT2 | WT3 | RAP60 | RAP140 | RAP220 | RAP300 | RAP380 | RAP460 | RAP540 | RAP620 | RAP700 | HU80 | HU120 | HU160 | rpd3Δ_1 | rpd3Δ_2 | rpd3Δ_3 | WT1 | WT2 | WT3 | AF100 | AF140 | AF180 |
| Cortical Patches | – | 0 | 0 | – | 0 | – | – | 0 | – | – | – | – | 1 | 0 | 2 | – | – | – | 0 | 2 | 1 | 1 | 4 | 2 |
| Bud | – | 2 | 1 | – | 0 | – | – | 0 | – | – | – | – | 0 | 0 | 0 | – | – | – | 0 | 0 | 0 | 2 | 1 | 3 |
| Bud Neck | – | 0 | 0 | – | 0 | – | – | 0 | – | – | – | – | 0 | 0 | 0 | – | – | – | 0 | 0 | 0 | 0 | 0 | 0 |
| Bud Site | – | 0 | 0 | – | 0 | – | – | 0 | – | – | – | – | 0 | 0 | 0 | – | – | – | – | – | – | – | – | – |
| Cell Periphery | – | 28 | 103 | – | 39 | – | – | 15 | – | – | – | – | 119 | 119 | 64 | – | – | – | 73 | 92 | 160 | 131 | 143 | 155 |
| Cytoplasm | – | 2 | 13 | – | 2 | – | – | 4 | – | – | – | – | 9 | 9 | 9 | – | – | – | 0 | 14 | 3 | 1 | 1 | 2 |
| Endoplasmic Reticulum | – | 3 | 5 | – | 2 | – | – | 1 | – | – | – | – | 2 | 2 | 0 | – | – | – | 0 | 3 | 4 | 3 | 3 | 3 |
| Endosome | – | 0 | 0 | – | 1 | – | – | 0 | – | – | – | – | 0 | 0 | 0 | – | – | – | 0 | 0 | 0 | 0 | 0 | 0 |
| Golgi | – | 0 | 0 | – | 0 | – | – | 0 | – | – | – | – | 0 | 0 | 0 | – | – | – | 0 | 0 | 0 | 1 | 0 | 0 |
| Mitochondria | – | 0 | 0 | – | 1 | – | – | 0 | – | – | – | – | 0 | 0 | 0 | – | – | – | 2 | 15 | 15 | 39 | 39 | 42 |
| Nucleus | – | 0 | 0 | – | 0 | – | – | 0 | – | – | – | – | 0 | 0 | 1 | – | – | – | 0 | 0 | 0 | 0 | 0 | 0 |
| Nuclear Periphery | – | 0 | 0 | – | 0 | – | – | 0 | – | – | – | – | 0 | 0 | 0 | – | – | – | 0 | 0 | 0 | 0 | 0 | 0 |
| Nucleolus | – | 0 | 0 | – | 0 | – | – | 0 | – | – | – | – | 0 | 0 | 1 | – | – | – | 0 | 0 | 0 | 0 | 0 | 0 |
| Peroxisomes | – | 0 | 0 | – | 0 | – | – | 0 | – | – | – | – | 0 | 0 | 0 | – | – | – | 0 | 0 | 0 | 0 | 0 | 0 |
| SpindlePole | – | 0 | 0 | – | 0 | – | – | 0 | – | – | – | – | 0 | 0 | 1 | – | – | – | 0 | 0 | 0 | 0 | 0 | 0 |
| Vac/Vac Membrane | – | 0 | 1 | – | 0 | – | – | 0 | – | – | – | – | 1 | 1 | 1 | – | – | – | 0 | 0 | 0 | 0 | 0 | 1 |
| Unique Cell Count | 33 | 119 | 45 | 20 | 129 | 129 | 74 | 77 | 132 | 189 | 184 | 197 | 215 | |||||||||||
| Labelled Cell Count | 35 | 123 | 45 | 20 | 132 | 131 | 79 | 77 | 132 | 189 | 184 | 197 | 215 | |||||||||||
Yeast GFP Assignment
Protein Abundance
| Screen | WT1 | WT2 | WT3 | RAP60 | RAP140 | RAP220 | RAP300 | RAP380 | RAP460 | RAP540 | RAP620 | RAP700 | HU80 | HU120 | HU160 | rpd3Δ_1 | rpd3Δ_2 | rpd3Δ_3 | AF100 | AF140 | AF180 |
|---|---|---|---|---|---|---|---|---|---|---|---|---|---|---|---|---|---|---|---|---|---|
| Mean Cell GFP Intensity (1e-4) | – | 178.4 | 156.1 | – | 192.0 | – | – | 251.4 | – | – | – | – | 127.4 | 127.4 | 117.8 | – | – | – | 153.3 | 162.1 | 181.5 |
| Std Deviation (1e-4) | – | 40.3 | 49.1 | – | 57.7 | – | – | 91.9 | – | – | – | – | 41.8 | 41.8 | 46.7 | – | – | – | 46.9 | 52.1 | 58.0 |
| Intensity Change (Log2) | – | – | – | – | 0.3 | – | – | 0.69 | – | – | – | – | -0.29 | -0.29 | -0.41 | – | – | – | -0.03 | 0.05 | 0.22 |
Localization Change
| Localization | RAP60 | RAP140 | RAP220 | RAP300 | RAP380 | RAP460 | RAP540 | RAP620 | RAP700 | HU80 | HU120 | HU160 | rpd3Δ_1 | rpd3Δ_2 | rpd3Δ_3 |
|---|---|---|---|---|---|---|---|---|---|---|---|---|---|---|---|
| Cortical Patches | – | 0 | – | – | 0 | – | – | – | – | 0 | 0 | 0 | – | – | – |
| Bud | – | 0 | – | – | 0 | – | – | – | – | 0 | 0 | 0 | – | – | – |
| Bud Neck | – | 0 | – | – | 0 | – | – | – | – | 0 | 0 | 0 | – | – | – |
| Bud Site | – | 0 | – | – | 0 | – | – | – | – | 0 | 0 | 0 | – | – | – |
| Cell Periphery | – | 0 | – | – | -1.3 | – | – | – | – | 1.5 | 1.5 | 0 | – | – | – |
| Cytoplasm | – | 0 | – | – | 0 | – | – | – | – | -1.1 | -1.1 | 0.3 | – | – | – |
| Endoplasmic Reticulum | – | 0 | – | – | 0 | – | – | – | – | 0 | 0 | 0 | – | – | – |
| Endosome | – | 0 | – | – | 0 | – | – | – | – | 0 | 0 | 0 | – | – | – |
| Golgi | – | 0 | – | – | 0 | – | – | – | – | 0 | 0 | 0 | – | – | – |
| Mitochondria | – | 0 | – | – | 0 | – | – | – | – | 0 | 0 | 0 | – | – | – |
| Nucleus | – | 0 | – | – | 0 | – | – | – | – | 0 | 0 | 0 | – | – | – |
| Nuclear Periphery | – | 0 | – | – | 0 | – | – | – | – | 0 | 0 | 0 | – | – | – |
| Nucleolus | – | 0 | – | – | 0 | – | – | – | – | 0 | 0 | 0 | – | – | – |
| Peroxisomes | – | 0 | – | – | 0 | – | – | – | – | 0 | 0 | 0 | – | – | – |
| SpindlePole | – | 0 | – | – | 0 | – | – | – | – | 0 | 0 | 0 | – | – | – |
| Vacuole | – | 0 | – | – | 0 | – | – | – | – | 0 | 0 | 0 | – | – | – |
External localization resources
Images






























Protein Concentration and Protein Localization Data
| R1 | R2 | R3 | ||||||||||||||||
|---|---|---|---|---|---|---|---|---|---|---|---|---|---|---|---|---|---|---|
| G1 Pre-START | G1 Post-START | S/G2 | Metaphase | Anaphase | Telophase | G1 Pre-START | G1 Post-START | S/G2 | Metaphase | Anaphase | Telophase | G1 Pre-START | G1 Post-START | S/G2 | Metaphase | Anaphase | Telophase | |
| Concentration | 3.1104 | 9.6931 | 7.9798 | 4.8364 | 5.9289 | 7.3734 | 7.2634 | 17.6067 | 11.6501 | 7.3365 | 9.3119 | 13.6944 | 6.4505 | 20.5174 | 9.3219 | 7.259 | 10.6626 | 14.5807 |
| Actin | 0.0515 | 0.0188 | 0.0611 | 0.0193 | 0.0344 | 0.0364 | 0.0336 | 0.0131 | 0.0215 | 0.0122 | 0.0319 | 0.0119 | 0.0258 | 0.0204 | 0.0231 | 0.017 | 0.0293 | 0.01 |
| Bud | 0.0257 | 0.0189 | 0.0082 | 0.012 | 0.0159 | 0.0199 | 0.0206 | 0.0196 | 0.0176 | 0.0264 | 0.0142 | 0.0136 | 0.0259 | 0.0121 | 0.0272 | 0.0286 | 0.0316 | 0.0122 |
| Bud Neck | 0.0086 | 0.0036 | 0.0067 | 0.0265 | 0.0341 | 0.0212 | 0.0085 | 0.0027 | 0.0157 | 0.0071 | 0.0228 | 0.0411 | 0.0075 | 0.0031 | 0.0081 | 0.0089 | 0.0049 | 0.0377 |
| Bud Periphery | 0.1188 | 0.0377 | 0.0564 | 0.1152 | 0.2231 | 0.1144 | 0.1099 | 0.0434 | 0.0716 | 0.18 | 0.109 | 0.1162 | 0.1186 | 0.0235 | 0.0864 | 0.1003 | 0.119 | 0.1008 |
| Bud Site | 0.0798 | 0.2792 | 0.0908 | 0.0769 | 0.0176 | 0.0101 | 0.1231 | 0.2995 | 0.1603 | 0.0776 | 0.0795 | 0.0165 | 0.1875 | 0.2958 | 0.1121 | 0.0346 | 0.0515 | 0.0077 |
| Cell Periphery | 0.2226 | 0.3383 | 0.3728 | 0.3504 | 0.3704 | 0.3974 | 0.4417 | 0.4683 | 0.4717 | 0.3701 | 0.4826 | 0.5608 | 0.3293 | 0.4865 | 0.4321 | 0.3997 | 0.4805 | 0.6017 |
| Cytoplasm | 0.1072 | 0.1473 | 0.1328 | 0.0969 | 0.106 | 0.197 | 0.0863 | 0.0678 | 0.1069 | 0.1941 | 0.1543 | 0.134 | 0.0657 | 0.0652 | 0.1178 | 0.2978 | 0.0622 | 0.0858 |
| Cytoplasmic Foci | 0.0214 | 0.018 | 0.0167 | 0.0205 | 0.0106 | 0.0153 | 0.012 | 0.0044 | 0.0107 | 0.0073 | 0.0258 | 0.0101 | 0.0085 | 0.0027 | 0.0108 | 0.0021 | 0.0157 | 0.0156 |
| Eisosomes | 0.0067 | 0.0072 | 0.015 | 0.0029 | 0.0108 | 0.006 | 0.0066 | 0.0071 | 0.0114 | 0.0032 | 0.0056 | 0.0035 | 0.0094 | 0.0162 | 0.0103 | 0.0012 | 0.0033 | 0.0045 |
| Endoplasmic Reticulum | 0.0217 | 0.0106 | 0.0162 | 0.0093 | 0.0122 | 0.011 | 0.0113 | 0.0058 | 0.0076 | 0.0137 | 0.007 | 0.0132 | 0.0197 | 0.0025 | 0.0109 | 0.0087 | 0.0081 | 0.0101 |
| Endosome | 0.031 | 0.0097 | 0.0163 | 0.0472 | 0.0587 | 0.0134 | 0.0107 | 0.0018 | 0.0079 | 0.0003 | 0.0113 | 0.0031 | 0.0104 | 0.0003 | 0.0117 | 0.0008 | 0.0064 | 0.0065 |
| Golgi | 0.0077 | 0.0024 | 0.0032 | 0.0244 | 0.0127 | 0.0057 | 0.0022 | 0.0009 | 0.0008 | 0.0005 | 0.0011 | 0.0005 | 0.0026 | 0.0003 | 0.001 | 0.001 | 0.0034 | 0.0025 |
| Lipid Particles | 0.0131 | 0.0042 | 0.0055 | 0.0146 | 0.027 | 0.0043 | 0.0064 | 0.0034 | 0.0026 | 0.0019 | 0.0039 | 0.0028 | 0.006 | 0.0016 | 0.0023 | 0.0021 | 0.0326 | 0.0031 |
| Mitochondria | 0.0175 | 0.0032 | 0.0163 | 0.0386 | 0.0088 | 0.0041 | 0.0066 | 0.0013 | 0.0029 | 0.005 | 0.0013 | 0.0012 | 0.0067 | 0.0017 | 0.0039 | 0.001 | 0.0321 | 0.0087 |
| None | 0.1693 | 0.0555 | 0.1183 | 0.0829 | 0.0022 | 0.1038 | 0.0789 | 0.0288 | 0.0547 | 0.0595 | 0.0161 | 0.0419 | 0.1305 | 0.0476 | 0.1026 | 0.017 | 0.0634 | 0.0329 |
| Nuclear Periphery | 0.0174 | 0.0015 | 0.002 | 0.0018 | 0.0025 | 0.0015 | 0.003 | 0.0021 | 0.0011 | 0.0012 | 0.0011 | 0.0011 | 0.0017 | 0.0006 | 0.0017 | 0.002 | 0.0033 | 0.001 |
| Nucleolus | 0.0028 | 0.0026 | 0.0048 | 0.0019 | 0.0026 | 0.0018 | 0.0022 | 0.0043 | 0.0031 | 0.003 | 0.001 | 0.001 | 0.0025 | 0.0008 | 0.0026 | 0.0046 | 0.0042 | 0.0036 |
| Nucleus | 0.0107 | 0.0016 | 0.0025 | 0.0016 | 0.002 | 0.0023 | 0.0047 | 0.0025 | 0.0016 | 0.0016 | 0.0012 | 0.0023 | 0.0018 | 0.0008 | 0.0018 | 0.0053 | 0.0057 | 0.0013 |
| Peroxisomes | 0.0031 | 0.0006 | 0.0025 | 0.0105 | 0.0033 | 0.0004 | 0.0007 | 0.0002 | 0.0025 | 0.0006 | 0.0009 | 0.0003 | 0.001 | 0.0002 | 0.0003 | 0.0002 | 0.0022 | 0.0012 |
| Punctate Nuclear | 0.0019 | 0.0007 | 0.002 | 0.0005 | 0.0007 | 0.0005 | 0.0022 | 0.0036 | 0.0008 | 0.0006 | 0.0003 | 0.0028 | 0.0007 | 0.0001 | 0.0004 | 0.001 | 0.0082 | 0.0008 |
| Vacuole | 0.0542 | 0.0373 | 0.0467 | 0.0424 | 0.0401 | 0.0304 | 0.0276 | 0.0191 | 0.026 | 0.0313 | 0.0271 | 0.0211 | 0.0364 | 0.0177 | 0.0309 | 0.063 | 0.0298 | 0.0507 |
| Vacuole Periphery | 0.0073 | 0.0009 | 0.0032 | 0.0036 | 0.0042 | 0.003 | 0.0013 | 0.0004 | 0.0011 | 0.0028 | 0.0019 | 0.0011 | 0.0017 | 0.0002 | 0.002 | 0.0031 | 0.0025 | 0.0017 |
Sequencing Data
| R1 | R2 | |||||||||
|---|---|---|---|---|---|---|---|---|---|---|
| G1 Post-START | S/G2 | Metaphase | Anaphase | Telophase | G1 Post-START | S/G2 | Metaphase | Anaphase | Telophase | |
| Gene Expression | 23.1715 | 11.1789 | 10.735 | 13.8453 | 14.783 | 5.1464 | 7.6462 | 8.7506 | 8.4328 | 8.1736 |
| Translational Efficiency | 1.6227 | 1.8451 | 1.0437 | 0.9041 | 0.8031 | 0.4849 | 0.4412 | 0.4133 | 0.4345 | 0.2873 |
Hit Data
| Dataset | Hit |
|---|---|
| Protein Concentration | ✘ |
| Protein Localization | ✘ |
| Gene Expression | ✘ |
| Translational Efficiency | ✘ |
Endocytosis
| Temp | Actin Patch (Sac6-tdTomato) | Cortical Patch (Sla1-GFP) | Late Endosome (Snf7-GFP) | Vacuole (Vph1-GFP) |
|---|---|---|---|---|
| 37℃ | ||||
| RT |
Cell Cycle Omics
CYCLoPs (Mep2-GFP)
| Gene / Allele | Actin Patch (Sac6-tdTomato) | Cortical Patch (Sla1-GFP) | Late Endosome (Snf7-GFP) | Vacuole (Sac6-tdTomato) |
|---|
| Gene | Images |
|---|
| Gene | Images |
|---|
Images are not yet available
Images are not yet available